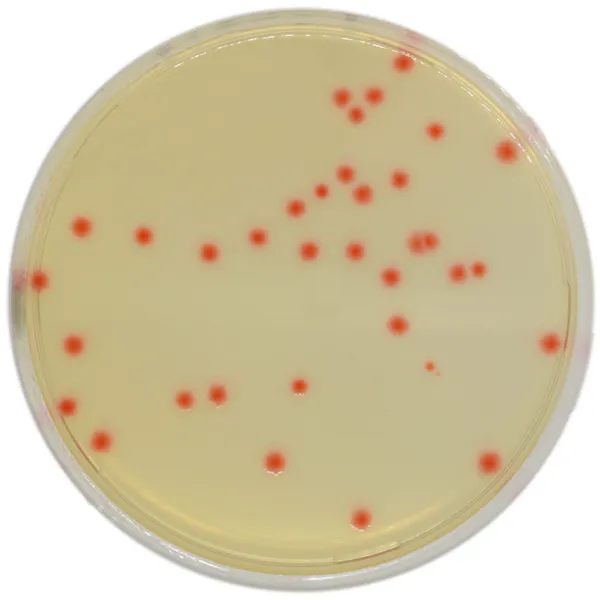
CHROMagar™ C. perfringens
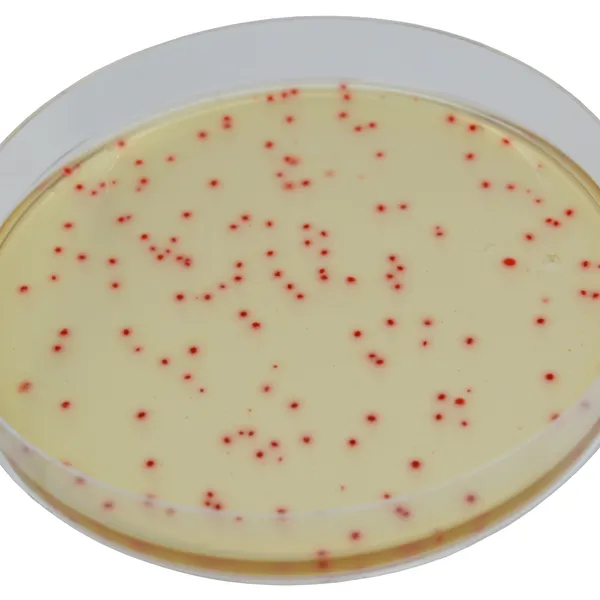
CHROMagar™ C. perfringens
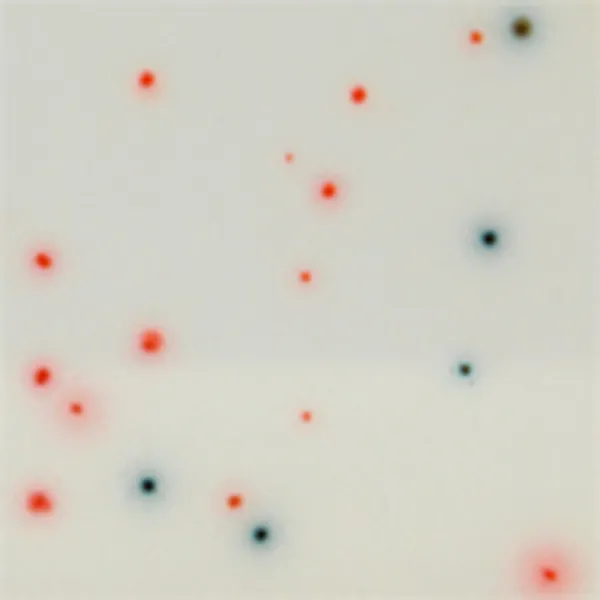
CHROMagar™ C. perfringens

Colonies Appearance

Clostridium perfringens
orange

C. difficile
green-blue to green
Performance
Performance
Clostridium perfringens is involved in food poisoning and animals’ infections.Beef, poultry, gravies, and dried or pre-cooked foods are common sources of C. perfringens infections. C. perfringens infection often occurs when foods are prepared in large quantities and kept warm for a long time before serving.
Although C. perfringens may live normally in the human intestine, illness is caused by eating food contaminated with large numbers of C. perfringens bacteria that produce enough toxin in the intestines to cause illness.
Everyone is susceptible to food poisoning from C. perfringens. The very young and elderly are most at risk of C. perfringens infection and can experience more severe symptoms that may last for 1 to 2 weeks. Complications, including dehydration, may occur in severe cases.
CDC - Centers for Disease Control and Prevention
1. To be used with pouring or surface méthode (by direct streaking, spreading or filtration technique) whereas with TSC medium bacteria have to be placed between two layers of agar in order to grow in black colonies.
2. Specific medium for Clostridium perfringens while TSC medium detects sulfate-reducing bacteria, including the non pathogens.
3. The orange coloration makes the vizualization very easy on the other hand, the spread of the colonies black color and the fact that they faint after a while in TSC medium (as described in the ISO 14189) makes the colony count difficult.
Composition

Technical Documents
Scientific Publications
2020
A comparative study on the use of selective media for the enumeration of Clostridium perfringens in poultry faeces
📄 Publication2020
Study of an acid phosphatase test for the confirmation of Clostridium perfringens directly from CHROMagar C.Perfringens agar medium
📄 Publication

Read more